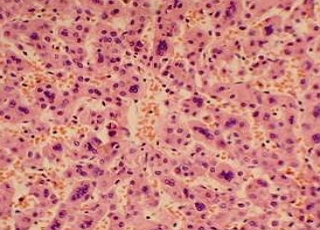

Мускатная Печень Фото
Мускатная Печень Фото 100 фотографий
Ялта Виноградная 20 Отель Фото
Табернемонтана Фото Домашний Цветок Уход
Xiaomi Note 10 Фото С Камеры
Ванная Комната Дизайн Фото В Квартире Недорого
Часы Патек Филиппе Цена Фото
Фото Голых 12 Лет Без Одежды
Россия Мелодрамы Фото
Пожелание Прекрасного Дня Мужчине Картинки
Краска Кеен Палитра Цветов Фото
Консервируем Помидоры Рецепты С Фото